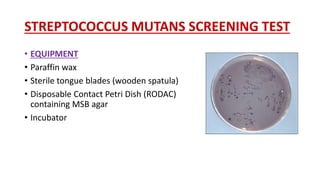
STREPTOCOCCUS MUTANS SCREENING TEST
• EQUIPMENT
• Paraffin wax
• Sterile tongue blades (wooden spatula)
• Disposable Contact Petri Dish (RODAC)
containing MSB agar
• Incubator

This document discusses various tests used to assess caries activity and susceptibility. It defines caries activity as referring to the speed of progression of caries lesions, while caries susceptibility refers to the inherent tendency to develop caries. Several tests are described that examine levels of cariogenic bacteria like lactobacilli or Streptococcus mutans in saliva, or that measure the ability of saliva to neutralize acids and buffer pH changes. These include bacterial culturing tests, color change assays, and tests analyzing the dissolution of enamel. Each test is outlined with the purpose, equipment, procedure, results, advantages and limitations.